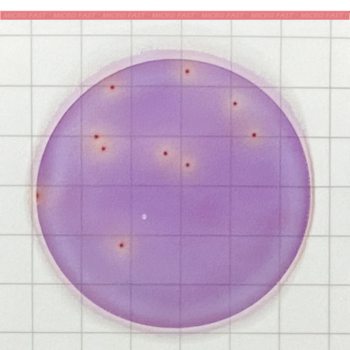
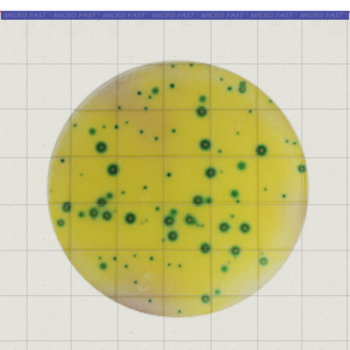
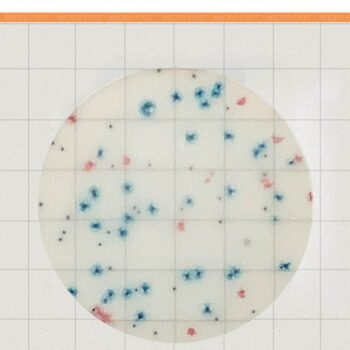
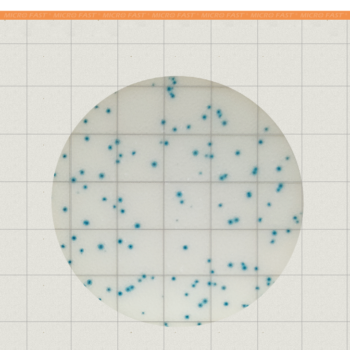

Microorganisms includes bacteria, fungi, Pathogen. Meizheng has Count Plate, Real Time PCR, Rapid Test Cassette, ATP Hygiene Monitoring System.
Bestsellers in Microorganism
PureTrust Surface Swabs PTS200
Order No.: PTS200It fits for Meizheng PureTrust Intelligent Fluorescence Detector(MF2000).
PureTrust Intelligent Fluorescence Detector for ATP Hygiene, Pesticide Residue and ALP
PureTrust Intelligent Fluorescence Detector is a multifunctional and potable intelligent luminometer which should be used with our pesticide residue fast detection reagents, surface swabs and alkaline phosphatase (ALP) detection kits.The instrument can do fast detection of adenosine triphosphate (ATP) to verify the surface cleaning effects, ALP level in milk and dairy products, and pesticide residue in target samples. It is widely used for on-site fast testing of food, health care products, cosmetics, pharmaceuticals, catering companies, health supervision, hospital or testing organizations and government regulatory authorities.The instrument is easy to use, portable and friendly human-device interaction without any training required. Follow this manual to get an easy start.
Microfast® Aerobic Count Plate (AC) AOAC Validated
MicroFast® Aerobic Count Plate (AC) is designed to determine total aerobic bacteria populations. The plate contains prefabricated type of medium, cold water gel and indicator (TTC). It is intended for the aerobic count test for food and environment.Brochure-Microbiology Test. PDFMeizheng Bio-Tech Company Overview. PDF
MF2000 ATP Hygiene Monitoring System
MF2000 Intelligent Fluorescence Detector is a handheld fluorescence detection instrument used with our surface sampling swabs.Combined with the detection reagent, the surface hygiene can be quickly detected and used to verify the cleaning effect. Widely used in food, health products, cosmetics, pharmaceuticals, catering enterprises, on-site rapid detection of health supervision, hospitals, government supervision and other departments.This instrument is easy to use, easy to carry, and friendly to human-computer interaction. No professional installation training is required, and you can easily operate it according to the instructions in the manual.
Microfast® Yeast & Mold Count Plate (YM) AOAC Validated
MicroFast® Yeast & Mold (YM) Count Plate is a sample-ready culture medium system which contains improved media, cold-water-soluble gelling agent l and indicator that facilitates colony enumeration. It is intended for the test for food and food material.Brochure-Microbiology Test. PDFMeizheng Bio-Tech Company Overview. PDF
Microfast® Staphyloccocus Aureus Count Plate (SA) AOAC Validated
MicroFast® Staphylococcus aureus(SA) Count Plates is a sample-ready-culture medium system which contains improved media, cold-water-soluble gelling agent and indicator that facilitates colony enumeration. It is intended for Staphylococcus aureus test for food, food material and production environment.Brochure-Microbiology Test. PDFMeizheng Bio-Tech Company Overview. PDF
Showing 1–12 of 19 results
MF2000 ATP Hygiene Monitoring System
MF2000 Intelligent Fluorescence Detector is a handheld fluorescence detection instrument used with our surface sampling swabs.Combined with the detection reagent, the surface hygiene can be quickly detected and used to verify the cleaning effect. Widely used in food, health products, cosmetics, pharmaceuticals, catering enterprises, on-site rapid detection of health supervision, hospitals, government supervision and other departments.This instrument is easy to use, easy to carry, and friendly to human-computer interaction. No professional installation training is required, and you can easily operate it according to the instructions in the manual.
Microfast® Staphylococcus aureus Confirmation Count Plate
Order No.: LR1005QMicroFast® Staphylococcus aureus Confirmation Count Plate contains improved media, cold-water-soluble gelling agent and indicator that facilitates colony enumeration. It is intended for colony confirmation of Staphylococcus aureus.
PureTrust Surface Swabs PTS100
Order No.: PTS100It fits for Meizheng PureTrust Intelligent Fluorescence Detector(MF1000Premium).
PureTrust Surface Swabs PTS200
Order No.: PTS200It fits for Meizheng PureTrust Intelligent Fluorescence Detector(MF2000).